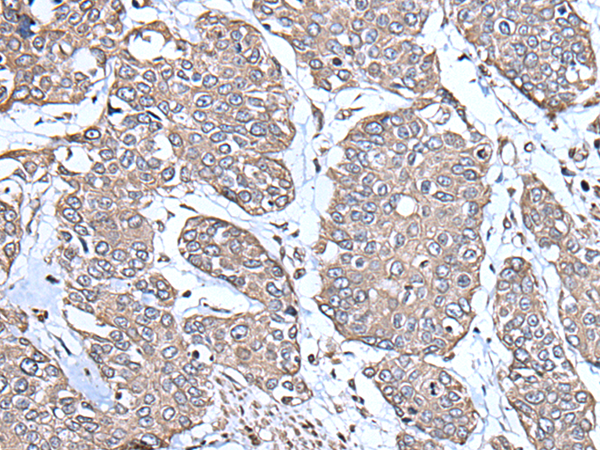
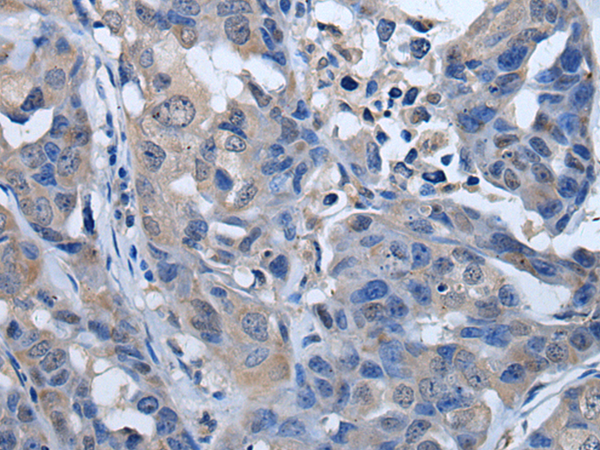
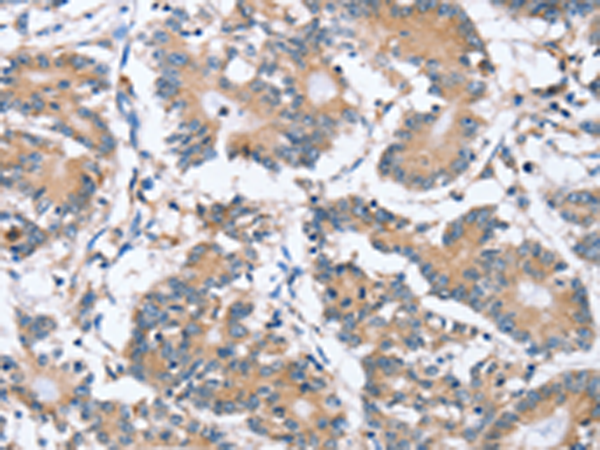
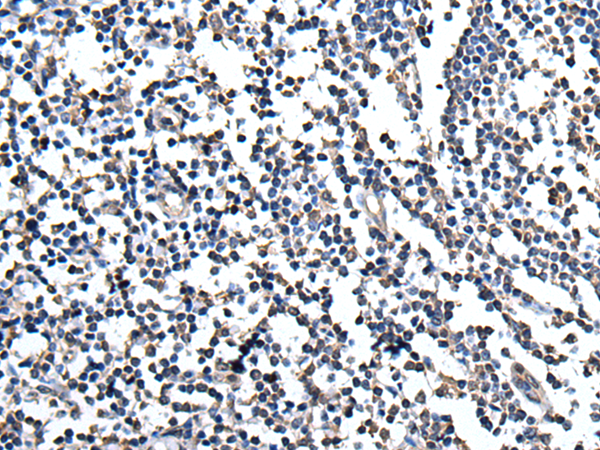

-
分类: 科研抗体货号: P08618别名: HPH2; PHD2; SM20; ECYT3; HALAH; HPH-2; HIFPH2; ZMYND6; C1orf12; HIF-PH2应用: IHC反应种属: Human, Mouse, Rat
-
分类: 科研抗体货号: P08629别名: PLRP1应用: WB,IHC反应种属: Human, Mouse, Rat
-
分类: 科研抗体货号: P08637别名: CYPA; CYPH; HEL-S-69p应用: WB,IHC反应种属: Human, Mouse, Rat
-
分类: 科研抗体货号: P08616别名: MPR; HPR6.6应用: WB,IHC反应种属: Human, Mouse, Rat
-
分类: 科研抗体货号: P08628别名: SAK; STK18; MCCRP2应用: IHC反应种属: Human, Mouse, Rat
-
分类: 科研抗体货号: P08635别名: RP-C; PP2Ac; PP2CA; PP2Calpha应用: WB,IHC反应种属: Human, Mouse, Rat
-
分类: 科研抗体货号: P08648别名: S4; p56; P26S4应用: WB,IHC反应种属: Human, Mouse, Rat
-
分类: 科研抗体货号: P08627别名: PLCzeta; NYD-SP27; PLC-zeta-1应用: IHC反应种属: Human
-
分类: 科研抗体货号: P08634别名: CMM10; HPOT1应用: IHC反应种属: Human
-
分类: 科研抗体货号: P08647别名: PRUNE; DRES17; HTCD37; NMIHBA; DRES-17; H-PRUNE应用: IHC反应种属: Human

鄂公网安备42018502007531号
鄂公网安备42018502007531号

